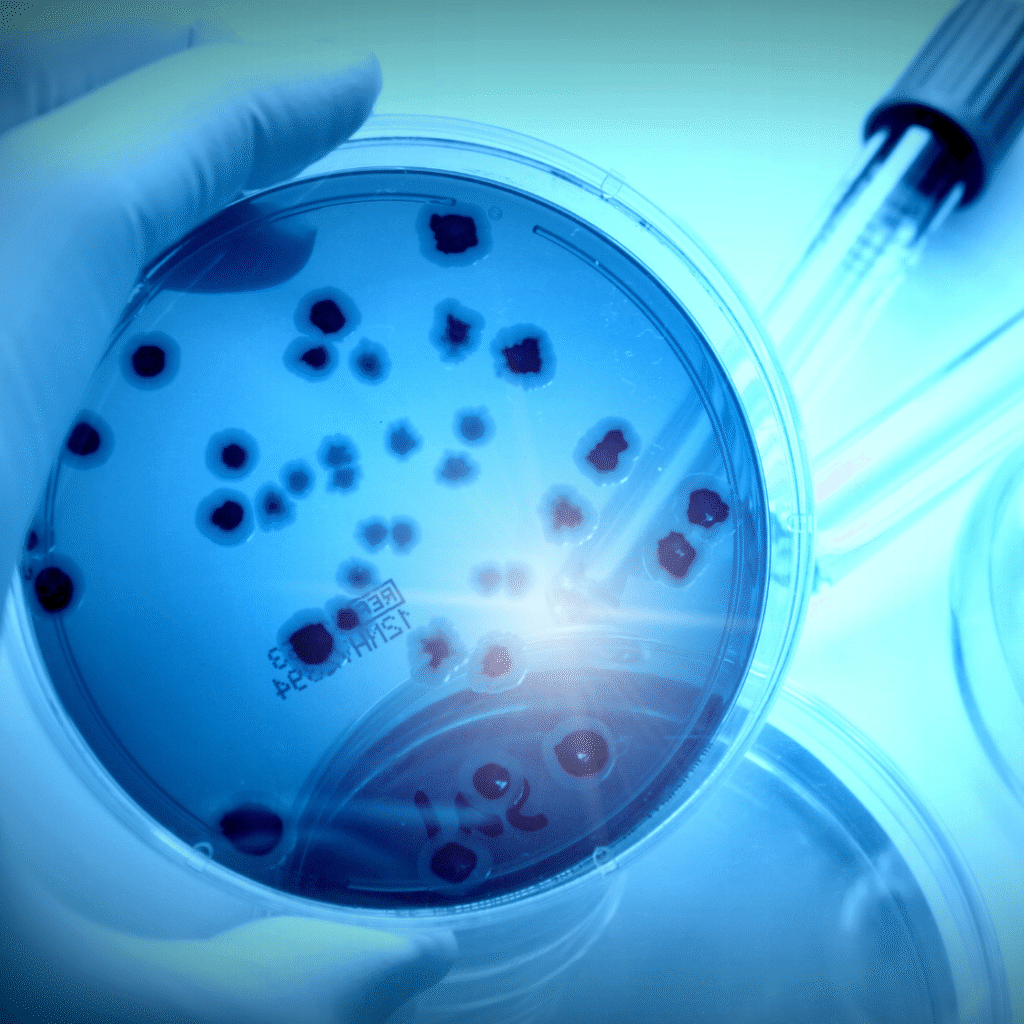
mikrobiologia

+
Years Of Experience
+
Happy Customers
%
Customer Satisfaction
Take charge of your health today
Uncover hidden health risks with our advanced testing solutions and live a longer, healthier life.
Explore our range of diagnostic tests
Czynnik krzepnięcia XI
321.48zł
Czynnik krzepnięcia V
321.48zł
Prokalcytonina
321.85zł
Białko S
433.19zł

Most frequently chosen tests